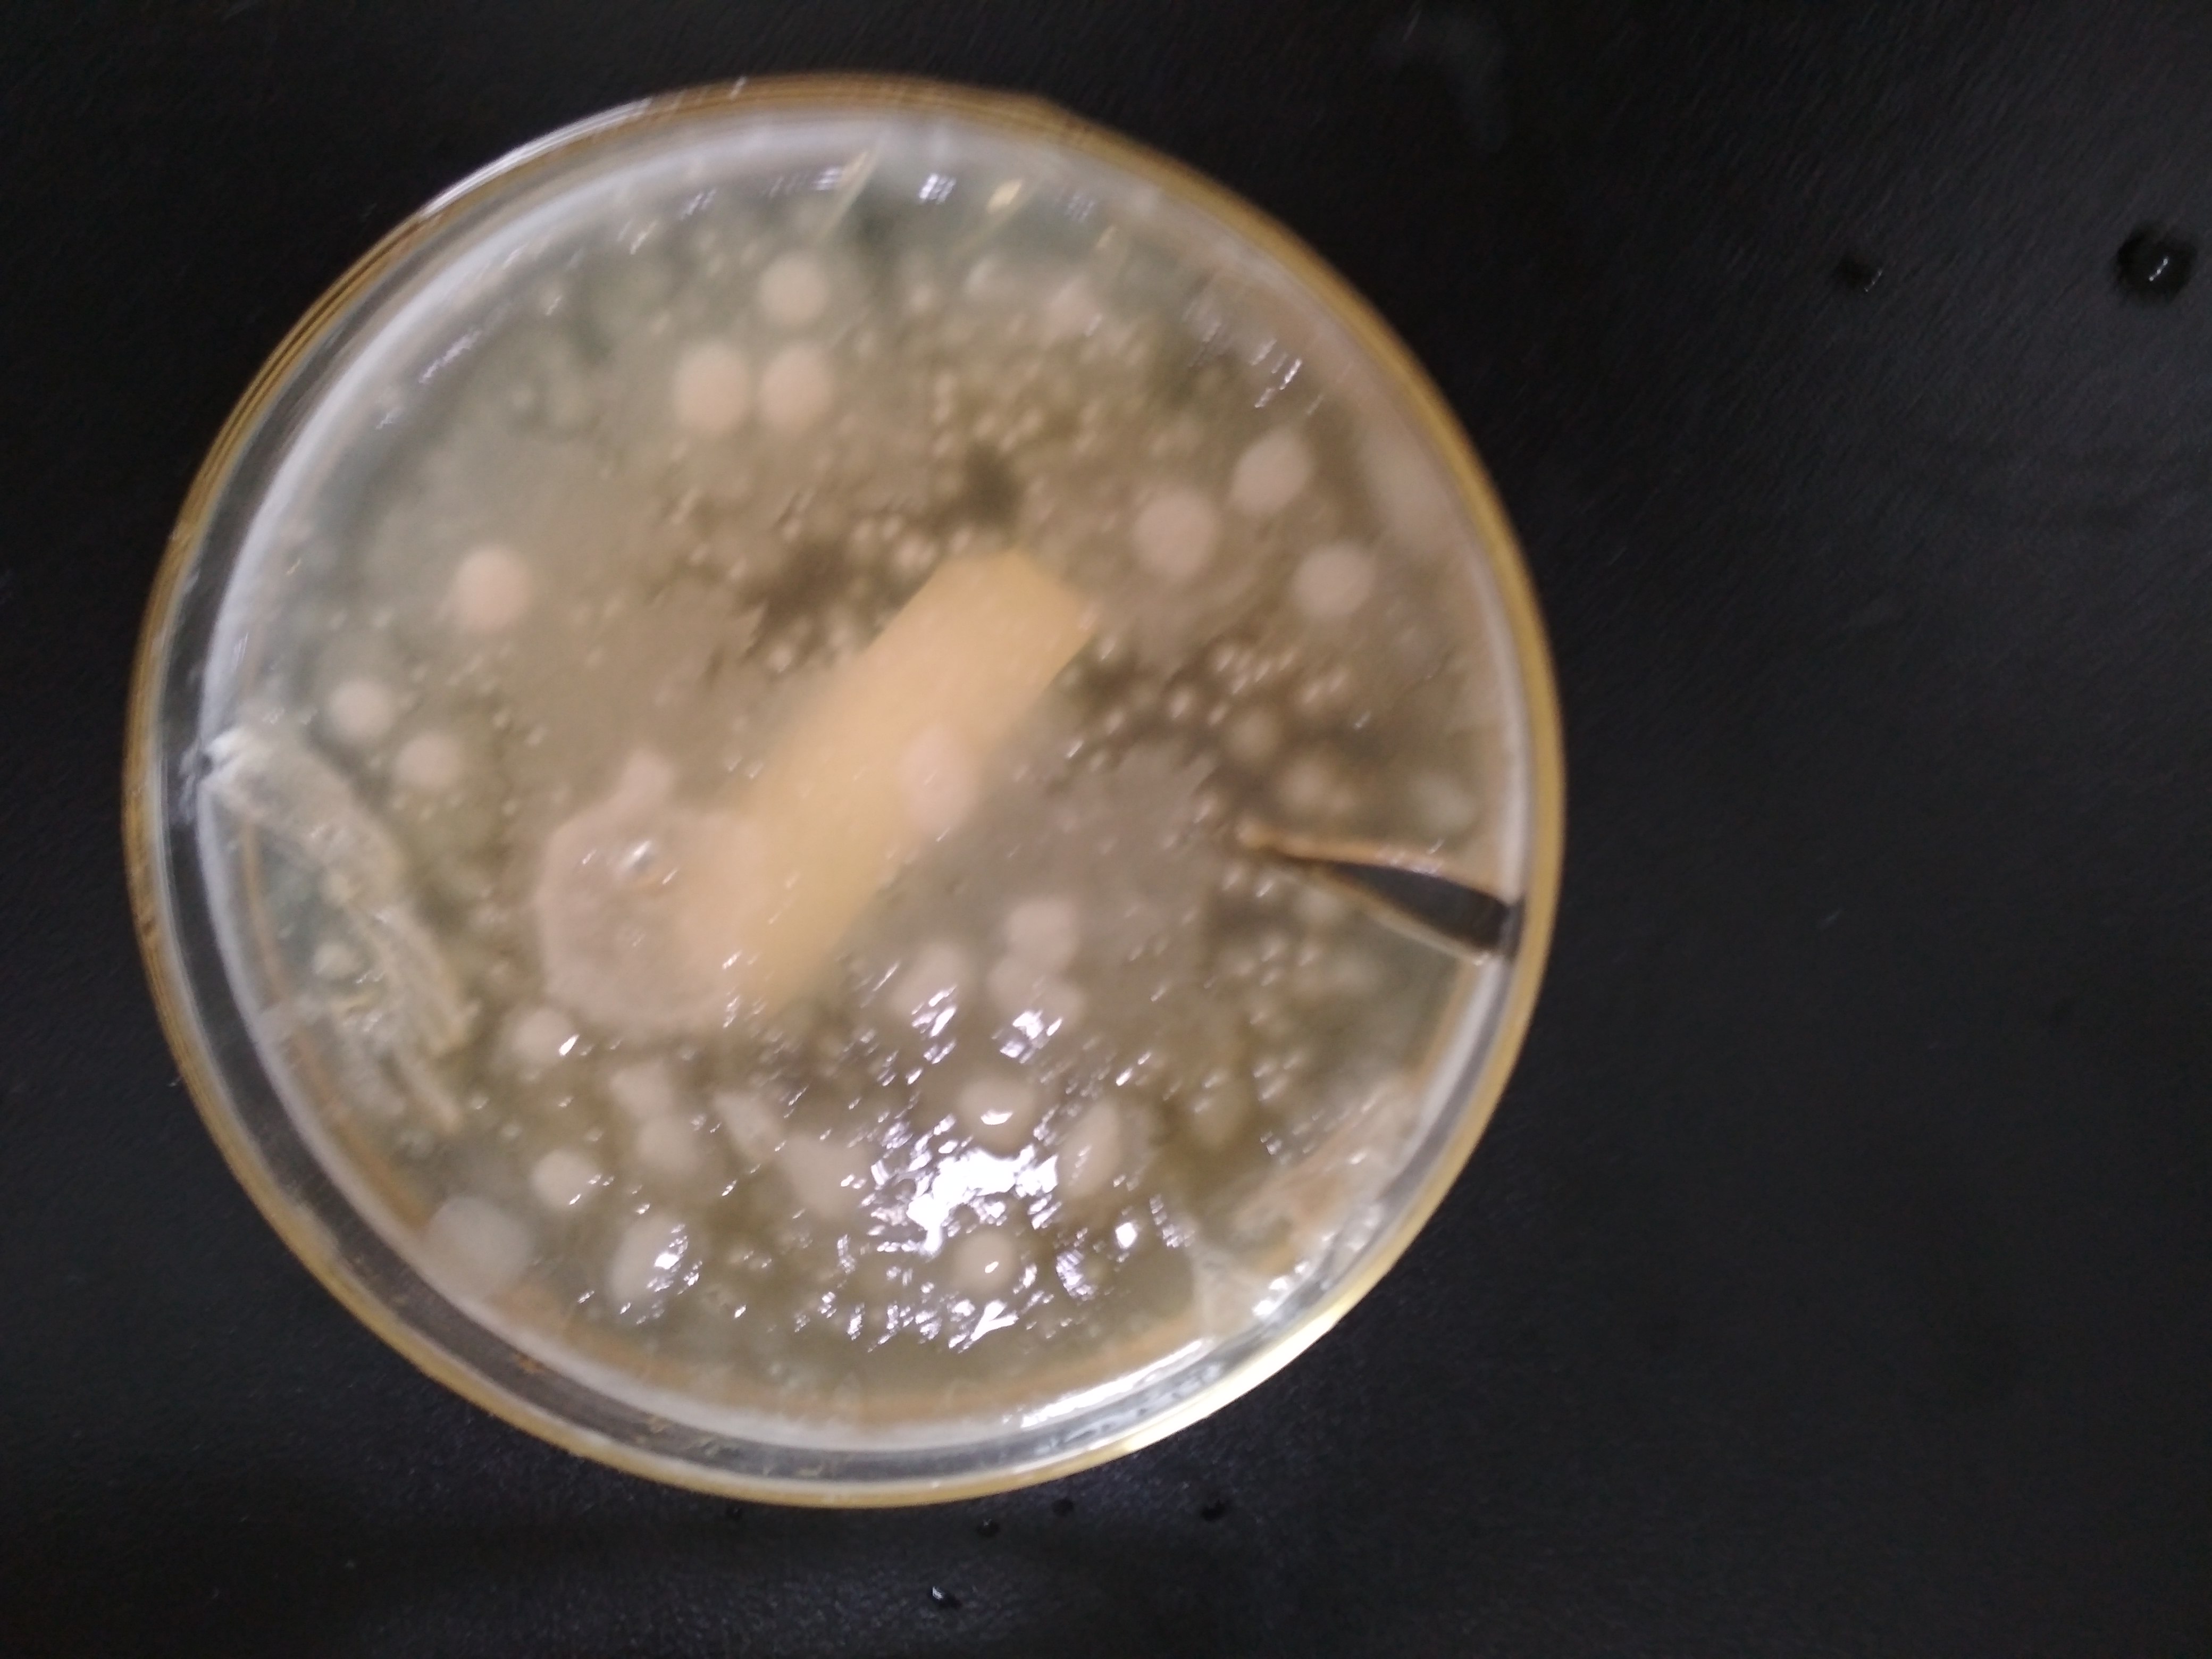
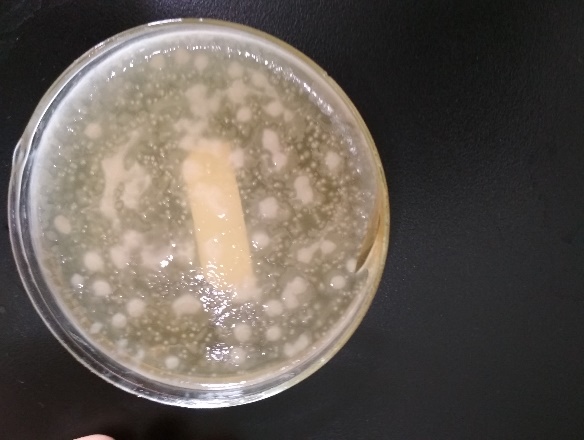

COD降解菌的筛选及其在石化废水处理中的应用毕业论文
2020-02-19 11:55:20
摘 要
随着石化工业发展,石化废水的污染日益严重,基于现状,本课题研究通过实验探讨了COD降解菌在石化废水生物技术处理上的应用价值。传统的石化废水处理技术有物理及化学技术,但相较于这两种技术而言,微生物技术处理石化废水有更大的优势,如高效、无二次污染等。
本课题研究主要针对石化废水中的化学需氧量限值,采用COD降解菌进行污水处理,观察菌株的生长情况以及COD的降解效率,分析探讨COD降解菌在石化废水处理中进行应用的可能性,以及实际应用价值,得到以下的结果:(1)本研究从南阳油田中分离纯化出高效的COD降解菌株,并对其进行生长条件的优化,得到pH为6.0,温度为35C,条件下菌株的生长情况最优,其生长曲线为标准的“S”型曲线,总周期为72 h。(2)通过单因素实验研究分析得到COD降解菌在pH为6.0~7.0范围内,温度为35C,以及较高的COD初始浓度下,有较高COD降解效率,最高效率为90.47%。(3)COD降解菌直接应用于石化废水中时,会因为实际废水中的复杂成分以及广泛的pH值,达不到预期的效果,所以要对废水进行预处理。
关键词:废水处理;COD降解菌;筛选;条件优化
Abstract
With the development of petrochemical industry, the pollution of petrochemical wastewater is becoming more and more serious. Based on the current situation, the application value of COD degrading bacteria in the biological treatment of petrochemical wastewater was discussed through experiments. Traditional petrochemical wastewater treatment technology has physical and chemical technology, but compared with these two technologies, microbial technology has more advantages, such as high efficiency, no secondary pollution.
This topic research value of chemical oxygen demand (COD), which mainly in petrochemical wastewater COD degradation bacteria is adopted to improve the sewage treatment, the growth of the strain and the degradation efficiency of COD and analyze COD degradation bacteria in the petrochemical wastewater treatment in the application possibility, as well as the practical application value, the following results: (1) this research from nanyang oil field in the purification efficiency of COD degradation bacteria strains, and carries on the optimization of growing conditions, get the pH is 6.0, the temperature of 35 C, under the condition of strains of the optimal growth conditions, the growth curve for the standard of "S" type curve, the total period of 72 h. (2) is obtained by single factor experiment study COD degradation bacteria within the scope of the pH 6.0 ~ 7.0, the temperature of 35 C, and the higher the initial concentration of COD, have higher COD degradation efficiency, the highest efficiency of 90.47%. (3) when COD degrading bacteria are directly applied to petrochemical wastewater, the wastewater shall be pretreated because the complex components in the actual wastewater and the extensive pH value cannot achieve the expected effect.
Keywords: effluent treatment; COD degradation bacterium; screening; Conditions optimization
目录
摘要 I
Abstract II
第一章 绪论 1
1.1 石化废水污染现状 1
1.2 石化废水的分类与危害 1
1.2.1 石化废水的分类 1
1.2.2 石化废水的危害 2
1.3 石化废水处理研究现状 3
1.3.1 传统石化废水处理技术 3
1.3.2 生物技术处理石化废水研究现状 3
1.4 微生物处理石化废水原理 4
1.5 研究目标、研究内容和拟解决的关键问题 4
1.5.1 研究课题的目的及意义 4
1.5.2 研究课题的主要内容 4
第二章 COD降解菌株的筛分、纯化 5
2.1 引言 5
2.2 实验原料及方法 5
2.2.1 菌源选取 5
2.2.2 主要仪器及试剂 5
2.2.3 实验方法 6
2.3 结果与讨论 8
2.3.1 COD降解菌的筛选、分离与保存 8
2.3.2 菌株生长曲线的研究 9
2.3.3 菌株的COD降解能力的研究 9
2.4 本章小结 10
第三章 COD降解菌生长条件优化 11
3.1引言 11
3.2 实验方法 11
3.3结果与讨论 11
3.3.1 不同蛋白胨浓度对COD降解菌生长的影响 11
3.3.2 不同酵母粉浓度对COD降解菌生长的影响 12
3.3.3 温度对COD降解菌生长的影响 13
3.3.4 pH对COD降解菌生长的影响 13
3.4本章小结 14
第四章 COD降解菌降解能力的研究 15
4.1引言 15
4.2 实验方法 15
4.3结果与讨论 15
4.3.1 温度对COD降解菌降解能力的影响 15
4.3.2 pH对COD降解菌降解能力的影响 16
4.3.3 初始COD浓度对COD降解菌降解效率的影响 17
4.3.4 接种量对COD降解菌降解效率的影响 18
4.4 COD降解菌在实际废水中的应用 18
4.4.1 引言 18
4.4.2 实验方法 19
4.4.3结果与讨论 19
4.5 本章小结 20
第五章 结论与展望 21
5.1 结论 21
5.2展望 21
参考文献 22
致谢 24
第一章 绪论
1.1 石化废水污染现状
石油被称为工业血液,在生活生产、能源及工业领域占据重要地位。但随着经济和社会的迅速发展,油类及其制品也被广泛地应用在各个领域和人们的日常生活当中,同时石油化工对水体污染的威胁也在增大,石化废水的污染也日渐严峻[1]。
在石油化工生产过程中,原料石油在经过裂解、分馏、重整等工序时会产生大量的石化废水如石炼油废水、化肥化纤等工业废水。同时由于石化工业产品繁多,工艺过程复杂,使得生产过程中排放的废水排放量以及废水污染物数量也十分庞大[25]。例如,石化废水中除了油、酚、硫、氰化物等还有多种如多环芳烃、杂环化合物等有机化学产品,以及砷、铬、镍、铍等重金属成分,其中含有酚、胺等类的废水还会带有明显的毒性[13]。
有数据显示,2015年,我国石化废水的总量、COD、氨氮、石油类、酚类和氰化物排放量分别占工业行业的7.0%、5.3%、8.8%、11.9%、5.2%和10.1%。由此可见石化废水是有毒污染物的重要来源,也是水生态风险的的重要因素。
为防治石化工业排放的废水对环境造成过大的污染,促进石油化学工业的技术进步以及可持续发展,环境保护部制定了石油化学工业污染物排放标准GB31517,标准中规定了石化工业的水污染以及大气污染物排放限值、监测和监督管理要求,并于2015-07-01实施。标准规定直接排放的石化废水pH值不得大于9或小于6,废水中的悬浮物不得大于70mg/L,COD值不得高于60mg/L,五日生化需氧量不得高于20mg/L。除此以外,废水中氨氮不得大于8.0mg/L,总氮不得大于40mg/L,总磷不得大于1.0mg/L,总有机碳不得高于20mg/L,石油类不得的大于5.0mg/L[24]。除了上述九种主要的指标,标准还规定了18种环境污染物的排放限值,包括有毒有机化合物以及各种重金属物质,本章不再赘述。
针对以上罗列出的排放限值,石化工业在废水处理方面应用了各类的物理化学以及生物技术,而本课题研究主要针对排放物中的化学需氧量在COD降解菌的作用是否能有效降低,同时观察其余指标如废水pH值以及含有类等在菌株处理后的变化,探究COD降解菌在石化废水处理中应用的价值[4-7]。
1.2 石化废水的分类与危害
1.2.1 石化废水的分类
石化工业的生产过程工序复杂繁多,这就导致在生产过程中产生的废水量大同时又具有不同复杂的特性,根据工序来源所产生污水的水质的不同,可以将石化废水分为以下几类:
(1)含油废水:含油废水是石化废水中含量最多的废水,顾名思义含油废水中的主要污染物就是油类,主要来自于石化工业中炼油设备清洗产生,主要包含石油、炼油产品以及有机溶剂等。油类污染物在水中的形态主要有浮油、乳化油和溶解油,在传统的含油废水处理技术中,应对不同形态的油类污染物需要用到不同的物理化学技术进行处理,但运用微生物处理方法能够高效地降低废水中的含油量,本课题研究主要就是运用COD降解菌针对含油废水处理的效果进行分析讨论[2-3]。
(2)含硫废水:含硫废水中硫污染物主要以硫化氢的形式存在,这就导致废水会散发强烈的恶臭,同时溶有硫化氢的废水具有腐蚀性,会损坏设备。挥发出的硫化氢气体具有毒性,会危害人体健康。在针对该类废水处理的过程中要时刻注意自身安全。
(3)含碱废水:含碱废水主要来自于石油加工后的洗涤水,因此废水中还含有少量的油类和碱。含碱废水的pH一般而言都在8以上,故若要应用微生物技术处理废水需要针对 废水进行预处理,否则过高的pH会抑制微生物的生长进而影响处理效果。
(3)含盐废水:盐含量高的废水处理不达标就进行排放后,若流入土壤容易造成土壤的盐渍化,盐渍化的土壤的表面会析出盐类的结晶,同时土壤中盐分过高会影响农作物的生长。
(4)含酚废水:酚类物质是一类中等毒性的化学物质,它对人体健康的危害极大,通过皮肤粘膜或是通过呼吸道吸入人体的酚类毒物在人体内进行积累后会导致人体中毒甚至昏迷死亡。不仅是对人类,酚类物质在进入水体和土壤时也会对水生动物以及农作物造成威胁,在农作物体内沉积的酚类最终又会通过食物链在人体内积累,从而对人体健康造成危害。不仅是石化行业,各大工业都会造成酚类废水的排放,因此含酚废水由于其危害大以及排放量高的原因已经成为危害环境的重要因素[32]。
1.2.2 石化废水的危害
进入土壤环境中的石化废水,能够结合土壤中的氮、磷,减少其在土壤中的含量从而影响农作物的生长,并且废水中含有的重金属如砷、铬、镍、铍等会通过自然中的食物链最终被人所吸收,导致癌症的发病率大大提高,对人们的身体健康造成严重的威胁。
若是排入河流中的石化废水中带有油类污染物,则会严重破坏自然景观。油类物质容易互聚成块形成油疙瘩,聚集在沿岸、码头,形成大片黑色的固体块,这些污染能长时间存在,同时难以清除干净。除此之外,水中的微生物在降解石化废水中的有机物的同时也会大量消耗水中的溶解氧,导致水中溶解氧的平衡遭到破坏,不利于水中动植物的生长发育,进而影响到整个水环境的生态。若受到污染的水体长期不处理,会导致水体进入厌氧的状态,使水质日益恶化,微生物大量滋生,甚至是散发恶臭[20]。
1.3 石化废水处理研究现状
1.3.1 传统石化废水处理技术
传统的石化废水处理技术包括物理处理、化学处理。其中物理处理技术中常见的主要有隔油法、气浮法、吸附法以及膜分离法。隔油法:主要用于含油废物的处理,利用隔油池将石化废水中的油类污染物进行初步分离,主要原理是油较水更轻,通常能自然上浮。气浮法:通过在水中生产高度分散的微小气泡,来吸附水中的悬浮物上浮到水面形成浮渣加以除去,该操作处理成本低且便于操作,同时具有不造成二次污染的特点。吸附法:利用多孔性固体对石化废水中的污染物进行吸附沉降来净化废水,但要进行二次分离。膜分离法:利用膜的选择透过性,选用不同种的膜通过渗析、反渗透、超滤等方法对石化废水进行处理,处理效果良好但膜成本较高,同时需要进行维护。在石化废水处理过程中发生了化学变化则被成为化学处理,主要油絮凝法和氧化法。絮凝法:该法是先向石化废水中加入一定量的絮凝剂,进而破坏废水中的胶体颗粒物质,从而形成直径较大的絮状物质,再通过沉降或者气浮的方式实现污染物质的分离。该法主要用于出去废水中的油类物质如乳化油等[28-31]。氧化法:顾名思义,就是将污染物进行氧化分解达到处理的目的,目前研究较多的一项高级氧化技术为光催化氧化技术,在光照条件下将污染物进行氧化处理,能够有效的达到处理的目的。近年来,光催化氧化技术在含油废水处理上的应用备受关注,陈士夫等利用空心玻璃负载二氧化钛在375W高压汞灯的照射下清楚水面上的油层,结果发现正十二烷的去除率达到了93.5%,甲苯的去除率达到了100%[25-27]。
1.3.2 生物技术处理石化废水研究现状
生物处理技术主要是利用不用种类的微生物通过新陈代谢的作用对石化废水中的污染物进行降解以达到废水处理的效果。主要有好氧法和厌氧法,好氧法主要用于处理石化废水中的胶体和溶解性的有机物,根据微生物的状态不同又可以分为活性污泥法和生物膜法两类,活性污泥法是在人工充氧的条件下,对污水和微生物群进行混合培养形成活性污泥,利用活性污泥的生物凝聚、吸附及氧化作用来除去废水中的有机污染物,再通过废水和污泥的分离达到废水净化的效果。生物膜法较活性污泥法不同是的,生物膜上的微生物固定生长,附着在载体的表面上,具有稳定的生态条件,同时具有生物量多,处理量大,运行管理较为方便的特点[8-11]。厌氧法与好氧法相似,不同的是所选用的微生物为厌氧微生物,处理过程中能耗较低,污泥产量很低,但是单独使用时,处理效果往往不达标,需要结合好氧法进行处理[2-4,16-17]。
相较于传统的物理及化学处理技术而言,生物技术具有无二次污染,处理成本低同时兼具优秀的处理效果等优点。因此生物法因其优势在石化废水的处理中占据着重要的地位[18-20]。
1.4 微生物处理石化废水原理
微生物所降解的石化废水中的污染物主要为各种有机物如脂肪烃、芳香烃等,二针对不同的有机污染物,微生物的降解途径和机理又不相同。一般认为在微生物的作用下,直链烷烃首先被氧化成醇,再进一步氧化成醛,最后反应成脂肪酸。相对于正构烷烃,带有支链的烷烃相对难降解,且支链越多难度越大。脂环烃类的降解则是通过环的断裂生成一元醇来进行代谢。芳香烃的降解则是在酶的作用下先生成二氢二酚类物质,并进一步氧化成儿茶酚类,再在另一种酶的作用下进一步降解[21]。
1.5 研究目标、研究内容和拟解决的关键问题
1.5.1 研究课题的目的及意义
随着我国石化行业的高速发展,伴随着而来的是严重的环境污染问题。石化行业排放的废水有着排放量大、污染物成分复杂、浓度高等特点,如果处理不达标就进行排放,将对环境造成难以想象的危害。针对石化行业的发展及石化废水的处理现状,本文从污染物的特点、危害、现状、处理技术、原理等方面进行论述,希望能为石化工业的废水处理及环境污染的治理做出贡献,也为将来微生物实际投入应用于石化废水的治理提供参考依据。
微生物法处理石化废水具有成本低、效率高、处理量大、技术成熟等优点,是目前石化废水的主要处理方法。但由于石化废水成分复杂,普通的微生物处理技术往往难以达到理想的效果。基于现状,本课题研究利用微生物中的一类COD降解菌来应用于石化废水的处理,以降低石化废水的中有机污染物的浓度为目标,使其达到石化废水排放的标准。同时对COD降解菌在实际环境下的COD降解能力进行探究,考察其在石化废水处理应用的效果。
1.5.2 研究课题的主要内容
本论文的研究内容主要包括以下几个方面:
(1)从南阳油田土壤中富集出COD降解菌液,从中筛选分离、纯化并保存得到高效COD降解菌株;
(2)对保存得到的COD降解菌株的最优生长条件及其在不同条件下的COD降解能力进行研究;
(3)对COD降解菌进行模拟石化废水应用研究。
第二章 COD降解菌株的筛分、纯化
2.1 引言
COD降解菌是一类好氧型微生物,它大量存在于油田、土壤、河底污泥、污水等复杂环境中。在有氧的环境下,COD降解菌能够通过生物的新陈代谢活动分解脂肪酸、芳香烃等有机物,以此来降低环境中的COD值,广泛应用于各类工业废水中的处理,能够有效改善油脂含量较高的水体和土壤。研究表明,在各种工业废水的处理中,单纯的微生物处理会因为废水成分的复杂如各种有毒物质、重金属、范围过大的pH值导致处理效果往往达不到预期的目标,但加入高效的COD降解菌剂能够有效地强化污水处理系统的处理效率。
本章从南阳油田的土壤中经富集培养、筛选分离,最后纯化保存高效COD降解菌,并对其菌株的COD降解能力及生长条件进行检测,为下一步使用单因素分析对其最适生长条件的探究奠定基础。
2.2 实验原料及方法
2.2.1 菌源选取
选取取自南阳油田的污染土壤作为菌种的富集来源,约取200 g,去除大颗粒杂志后,仔细混合研磨,并干燥48 h。
2.2.2 主要仪器及试剂
本章实验所用的主要仪器及设备如下页表2-1、2-2所示。
以上是毕业论文大纲或资料介绍,该课题完整毕业论文、开题报告、任务书、程序设计、图纸设计等资料请添加微信获取,微信号:bysjorg。
相关图片展示:

您可能感兴趣的文章
- 用于甲醇制烯烃反应的SAPO-34/ZSM-5复合催化剂的原位水热结晶合成外文翻译资料
 - 硫化氢在活体的化学发光探针成像外文翻译资料
 - 全色发射型ESIPT荧光团对某些酸及其共轭碱负离子识别的颜色变化外文翻译资料
 - 一种用于成像神经元细胞和海马组织中NMDA受体附近内源性ONOO-的双光子荧光探针外文翻译资料
 - 表面功能化的Ui0-66/pebax基超薄复合中控纤维气体分离膜外文翻译资料
 - 金属有机框架中的可逆调节对本二酚/醌反应:固态固定化分子开关外文翻译资料
 - 二维MXene薄片的尺寸相关物理和电化学性质外文翻译资料
 - 将制甲烷的Co催化剂转化为产甲醇的In@Co催化剂外文翻译资料
 - MXene分子筛膜用于高效气体分离外文翻译资料
 - 模板导向合成具有排列通道和增强药物有效荷载的立方环糊精聚合物外文翻译资料
 

        
            
